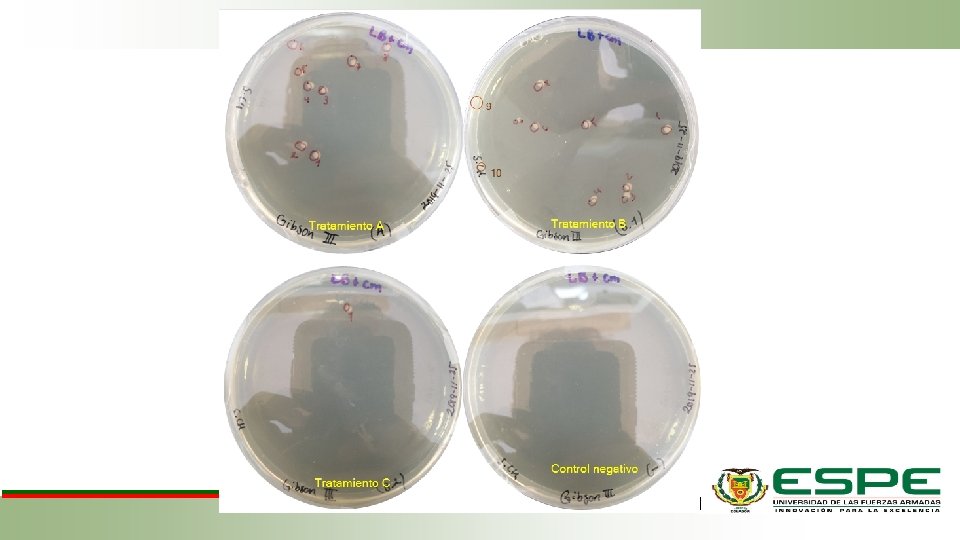

DEPARTAMENTO DE CIENCIAS DE LA VIDA Y DE

- Slides: 27
DEPARTAMENTO DE CIENCIAS DE LA VIDA Y DE LA AGRICULTURA INGENIERÍA EN BIOTECNOLOGÍA Adaptación del sistema CRISPR /Cas 9 para edición genética en el microorganismo no modelo Burkholderia sacchari. Autor: Sebastián Andrés Chile Miranda Director: Ing. Francisco Javier Flores Flor, Ph. D. Sangolquí, septiembre 2020
JUSTIFICACIÓN DEL PROBLEMA Xilitol Burkholderia sacchari Moléculas valor industrial Ac. Xilónico PHA Fuentes carbono renovables (Brämer, Vandamme, Da Silva, Gomez, & Steinbüchel, 2001; Guamán et al. , 2018)
Dificultades Vectores de clonación Requerimientos Herramientas de edición Resistencia Antibióticos Construir microorganismos (Lefebre & Valvano, 2002; Y. Jiang et al. , 2015) CRISPR/Cas 9 Modificaciones precisas Eficiencias elevadas
OBJETIVOS Objetivo General • Adaptar el sistema CRISPR /Cas 9 para edición genética en el microorganismo no modelo Burkholderia sacchari. Objetivos específicos • Caracterizar de forma microbiológica a Burkholderia sacchari. • Diseñar in silico el plásmido para la expresión de la proteína Cas 9 en Burkholderia sacchari. • Construir el plásmido de expresión de la proteína Cas 9, para Burkholderia sacchari, mediante la técnica GIBSON assembly. • Obtener clones de Burkholderia sacchari, que contengan los plásmidos de expresión de la proteína Cas 9.
MARCO TEÓRICO Sistema CRISPR/Cas 9 (You et al. , 2019; Gibson et al. , 2009; Geneious, 2020) Gibson assembly
MATERIALES Y MÉTODOS Caracterización • UTE_PM_S 019 microbiológica de • UTE_EM_S 020 Burkholderia sacchari Pruebas de clonación en Burkholderia sacchari • p. A 1 C_RFP, p. B 5 C_GFP y p. S 5 C_GFP Diseño in silico PCR • Gibson • Primers • Platinum ™ • Phusion ™ Reacciones Gibson • 3 ensayos Comprobaciones • PCR • Enzimas de restricción
Caracterización microbiológica de Burkholderia sacchari OD 600 = 0, 1 BHI+Kan MM 30°C 5000 rpm 3 minutos H 2 O 2 al 3% S 020 BHI+Kan 30°C Muestra y blanco (x 3) Cytation™ 5 a 30°C OD 600 durante 22: 30 (Brämer et al. , 2001)
Fase adaptación: 3 h Fase exponencial: 3, 5 h – 8 h
Pruebas de clonación en Burkholderia sacchari Preparación células competentes Rb. Cl 2 p. A 1 C_RFP, p. B 5 C_GFP y p. S 5 C_GFP Transformación Shock térmico (Hanahan, 1983)
p. A 1 C_RFP p. S 5 C_GFP p. B 5 C_GFP Control Negativo
Diseño in silico del ensamble Gibson • ORI (1908 pb) → p. BBR 5 K_RFP Cm Cas 9 ORI Plásmido expresión proteína Cas 9 (Invitrogen TM, 2014) • Cm (989 pb) → p. B 5 C_GFP • Cas 9 (9727 pb) → p. Cas 9 • Cas 1(4551 pb) • Cas 2(3216 pb) • Cas 3(1960 pb)
Diseño de primers Gene. Art® Primer and Construct Design Tool Complementariedad
Comprobaciones PCR: Cas 3_fwd y Ori_rev (4872 pb). ER: Sal. I y Kpn. I (8449 pb y 4174 pb). Sac. I (2912 pb)
Estandarización de las reacciones Gibson T amb. 45 min Primer ensayo -2µl de Buffer de reacción 5 X -1µl de Mix de enzima 10 X -140 ng de cada fragmento de PCR (6. 11 µl) -0. 89 µl de Agua ultra pura Escherichia coli DH 10 B T= 50°C 45 min Segundo ensayo -2µl de Buffer de reacción 5 X -1µl de Mix de enzima 10 X -200 ng de cada fragmento de PCR (4. 48 µl) -2. 52 µl de Agua ultra pura Escherichia coli DH 10 B
Primer ensayo
Segundo Ensayo
Tercer ensayo Tratamiento A Vector: Cm+Ori Inserto: Cas 1+Cas 2+Cas 3 -2µl de Buffer de reacción 5 X -1µl de Mix de enzima 10 X -20 ng de Vector (0. 57 µl) -134. 3 ng de Inserto (2. 1 µl) -4. 33 µl de Agua ultra pura Relación molar 2: 1 Tratamiento B T amb. 45 min Escherichia coli DH 10 B -4µl de Buffer de reacción 5 X -2µl de Mix de enzima 10 X -100 ng de Vector (2. 87 µl) -671. 5 ng de Inserto (10. 53 µl) -0. 6 µl de Agua ultra pura Escherichia coli DH 10 B
Vector: Cm Inserto: Ori - Cas 1+Cas 2+Cas 3 T amb. 45 min Tratamiento C Relación molar 1: 1 -2µl de Buffer de reacción 5 X -1µl de Mix de enzima 10 X -30 ng de Vector (0. 15 µl) -295 ng de Inserto Ori (5 µl) 57. 8 ng de Inserto (0. 35 µl) -1. 5 µl de Agua ultra pura Escherichia coli DH 10 B
DISCUSIÓN Caracterización microbiológica de Burkholderia sacchari • (Brämer et al. , 2001): B. sacchari positivo tanto a catalasa como para oxidasa • (Souza, Gonçalves, & Fonseca, 2011). Adaptación: glucosa (3. 0 h), fructosa (5. 5 h. - 6. 0 h. ) sacarosa (3. 5 h. - 4. 0 h). Diseño y construcción del plásmido para la expresión de la endonucleasa Cas 9 mediante el ensamblaje de Gibson. • (Pyhtila, 2016): Actividad exonucleasa de la reacción y formación de estructuras secundarias • Autodímeros: Ori_fwd (-9. 8 kcal/mol) • Heterodímeros: Ori_fwd con Cas 3_fwd (-8, 2 kcal / mol) Cas 1_rev (-7. 55 kcal/mol ) Cas 1_fwd con Cm_fwd (-7, 48 kcal / mol) Cas 2_fwd (Δ G °) -7. 31 kcal/mol Cas 2_rev con Cas 3_rev ( -8, 7 kcal / mol) Cas 3_rev con Cm_rev ( -8, 13 kcal / mol) • (Gao, Wolf, & Georgiadis, 2006; Schreck et al. , 2015): (0 < Δ G °), afectan las propiedades cinéticas de hibridación de los oligonucleótidos
DISCUSIÓN Clonación de Burkholderia sacchari • (Barreno, 2018) Método de Rb. Cl 2, eficiencias: 3. 66*105 y 2*106 UFC/µg DNA • BBR 1, (Garcez, Cabrera, & Ferreira, 2009) transformaciones exitosas en B. sacchari • (Guamán et al. , 2018): Secuencias de importancia en la interacción con la proteína iniciadora de la replicación: Dna. A y otras con proteínas relevantes para la replicación y estabilidad del plásmido en bacterias Gram-negativas.
CONCLUSIONES cepa S 019, se encuentra contaminada con algún microorganismo negativo para oxidasa Burkholderia sacchari a 30°C y en medio BHI, describe la fase de adaptación de 3 a 3. 5 horas y su fase de crecimiento exponencial se encuentra en el rango de 3. 5 a 8. 5 horas. Se realizó el diseño in silico del plásmido de expresión de la endonucleasa Cas 9, capaz de expresarse en Burkholderia sacchari. La formación de estructuras secundarias durante la reacción de Gibson, dificultaron el ensamblaje del plásmido de expresión de la endonucleasa Cas 9. No se logró construir in vivo el sistema CRISPR/Cas 9 en el organismo no modelo Burkholderia sacchari. Se comprobó de manera cualitativa la eficiencia de clonación de la bacteria Burkholderia sacchari.
RECOMENDACIONES Identificación molecular de las muestras existentes en el cepario del laboratorio CENBIO de la Universidad UTE, previamente identificadas como pertenecientes a la especie Burkholderia sacchari. Realizar un análisis previo de las estructuras secundarias en el ensamble de Gibson. Se debe continuar desarrollando herramientas de edición genética para el microorganismo Burkholderia sacchari, debido a su gran potencial de producción de moléculas de interés industrial
Agradecimientos Francisco Flores Ph. D. Alma Koch M. Sc. Familia y amigos
No importa lo lento que vayas mientras no te detengas -Confucio-